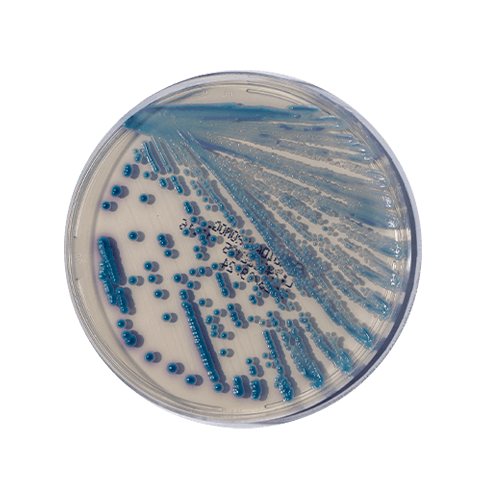
RSTGTDSTCTSGTV FETAGESTGEATGYRVET

O Candida Cromogênico é um meio de cultura especializado destinado ao isolamento e diferenciação rápida de espécies de Candida, um grupo de fungos patogênicos muito pesquisado e de importância clínica. Por ser um meio cromogênico, ele contém substratos que possibilitam a diferenciação visual direta das colônias das diferentes espécies.